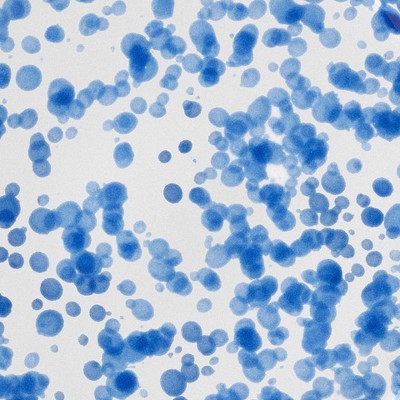

Sponsored



10.5" Stoneware Round Rim Dinner Plate - Room Essentials™
New at target
$6.00
In Stock
Eligible for registries and wish lists
At a glance
Sponsored
About this item
Highlights
- Round-rim dinner plate in blue
- Made of stoneware
- Raised rim
- Microwave and dishwasher safe
Description
Add a touch of elegance to your dining table with this Stoneware Round Rim Dinner Plate from Room Essentials™. Made of stoneware in blue, this round dinner plate with a raised rim is great for serving a variety of appetizers, main courses and deserts. Best of all, the plate is both dishwasher and microwave safe for easy cleaning and reheating.
Room Essentials™: Everyday Value
Room Essentials™: Everyday Value
Features: Round (shape)
Number of Pieces: 1
Dimensions (Overall): 10.5 Inches (L), 10.5 Inches (W)
Service For: 1
Material: Stoneware
Care & Cleaning: Microwave-Safe, Dishwasher-Safe
TCIN: 94687075
UPC: 199268694103
Item Number (DPCI): 200-04-8960
Origin: Imported
If the item details aren’t accurate or complete, we want to know about it.
Shipping details
Estimated ship dimensions: 10.5 inches length x 10.5 inches width x 1.25 inches height
Estimated ship weight: 1.91 pounds
Return details
This item can be returned to any Target store or Target.com.
This item must be returned within 365 days of the date it was purchased in store, shipped, delivered by a Shipt shopper, or made ready for pickup.
See the return policy for complete information.